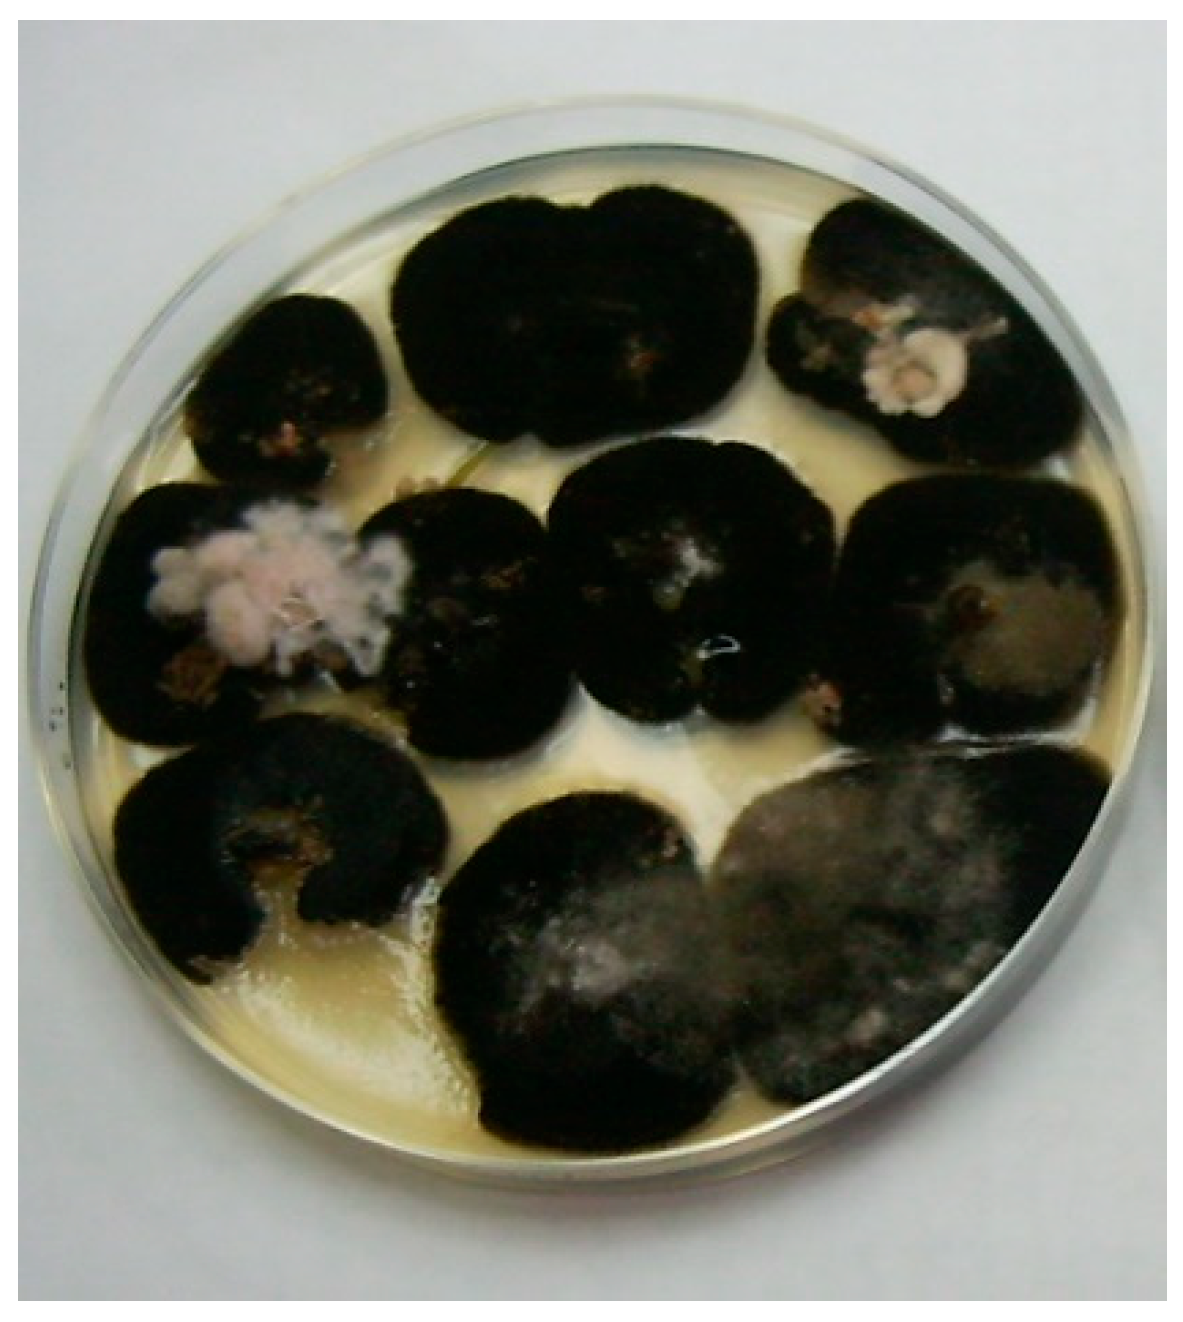
Agronomy 14 01322 g002

The Infection of Barley at Different Growth Stages by Bipolaris sorokiniana and Its Effect on Plant Yield and Sowing Value
Abstract
1. Introduction
2. Materials and Methods
2.1. Plant Infection at Different Development Stages
2.1.1. Isolation of Fungus Isolate and Its Aggressiveness
2.1.2. Preparation of the Inoculum
2.1.3. Laboratory Experiment
2.2. Statistical Analysis
3. Results
3.1. Effect of Infection at Different Vegetation Stages of Plants on YPP, TKW and GC
3.2. Seed Health Analysis
4. Discussion
5. Conclusions
Author Contributions
Funding
Data Availability Statement
Conflicts of Interest
References
- Manamgoda, D.S.; Rossman, A.Y.; Castlebury, L.A.; Crous, P.W.; Madrid, H.; Chukeatirote, E.; Hyde, K.D. The genus Bipolaris. Stud. Mycol. 2014, 79, 221–288. [Google Scholar] [CrossRef]
- Kiesling, R.L. The diseases of barley. In Agronomy Monographs; Rasmussen, D.C., Ed.; ASA and SSSA: Madison, WI, USA, 1985; pp. 269–308. [Google Scholar]
- Wiewióra, B. Podatność jęczmienia jarego na porażenie przez Bipolaris sorokiniana (Sacc.) Shoem. sprawcę plamistości liści. Biul. Inst. Hod. I Aklim. Roślin 2009, 252, 187–199. [Google Scholar]
- Kiecana, I.; Cegiełko, M.; Mielniczuk, E. Fungi colonizing the sowing material of turfgrasses considering susceptibility of cultivars to selected pathogens. Acta Sci. Pol. Hortorum Cultus 2012, 5, 153–168. [Google Scholar]
- Kiecana, I.; Cegiełko, M.; Mielniczuk, E. Fungi occurred on turfgrasses in lawn maintenance. Acta Sci. Pol. Hortorum Cultus 2015, 14, 63–80. [Google Scholar]
- Kumar, J.; Hückelhoven, R.; Beckhove, U.; Nagarajan, S.; Kogel, K.H. A compromised Mlo pathway affects the response of barley to the necrotrophic fungus Bipolaris sorokiniana (teleomorph: Cochliobolus sativus) and its toxins. Am. Phytopathol. Soc. 2001, 91, 127–133. [Google Scholar] [CrossRef]
- Fletch, T.G., Jr.; Steffenson, B.J. Identification of Cochliobolus sativus isolates expressing differential virulence on two-row barley genotypes from North Dacota. Can. J. Plant Pathol. 1994, 16, 202–206. [Google Scholar] [CrossRef]
- Ghazvini, H.; Tekauz, A. Virulence Diversity in the Population of Bipolaris sorokiniana. Plant Dis. 2007, 91, 814–821. [Google Scholar] [CrossRef][Green Version]
- Rysbekova, A.M.; Sultanova, N.Z. Biological make-up of soil and seed infection by the root rot pathogen (Bipolaris sorokiniana) of barley in the Southeastern Region of Kazakhstan. Rhizosphere 2022, 22, 100536. [Google Scholar] [CrossRef]
- Al-Sadi, A.M. Bipolaris sorokiniana-Induced Black Point, Common Root Rot, and Spot Blotch Diseases of Wheat: A Review. Front. Cell. Infect. Microbiol. 2021, 11, 584899. [Google Scholar] [CrossRef]
- Sharma, P.; Mishra, S.; Singroha, G.; Kumar, R.S.; Singh, S.K.; Singh, G.P. Phylogeographic Diversity Analysis of Bipolaris sorokiniana (Sacc.) Shoemaker Causing Spot Blotch Disease in Wheat and Barley. Genes 2022, 13, 2206. [Google Scholar] [CrossRef]
- Barba, J.T.; Reis, E.M.; Forcelini, C.A. Comparison of methods for the detection of Bipolaris sorokiniana in barley seeds. Fitopatol. Bras. 2002, 27, 389–394. [Google Scholar]
- Christensen, J.J. Longevity of fungi in barley kernels. Pl. Dis. Reprt. 1963, 47, 639–642. [Google Scholar]
- Clark, R.V.; Wallen, V.R. Seed infection of barley by Cochliobolus sativus and its influence on yield. Can. Plant Dis. Surv. 1969, 49, 60–64. [Google Scholar]
- Grey, W.E.; Mathre, D.E. Reaction of spring barleys to common root rot and its effect on yield components. Can. J. Pl. Sci. 1984, 64, 245–253. [Google Scholar] [CrossRef]
- Łacicowa, B.; Pięta, D. Podatność różnych odmian jęczmienia jarego na porażenie przez Drechslera sorokiniana (Sacc.) Subram. et. Jain. Hod. Rośl. Aklim. 1991, 35, 53–59. [Google Scholar]
- Christensen, J.J. Studies on the parasitism of Helminthosporium sativum. Univ. Minn. Agric. Exp. Stn. Tech. Bull. 1922, 11, 1–42. [Google Scholar]
- Eng-Chong-Pua, R.R.; Pelletier, H.R.; Klinck, H.R. Seedling blight, spot blotch and common root rot in Quebec and their effect on grain yield in barley. Can. J. Plant Pathol. 1985, 7, 395–401. [Google Scholar]
- Couture, L.; Sutton, J.C. Relation of weather variables and host factors to incidence of airborne spores of Bipolaris sorokiniana. Can. J. Bot. 1978, 56, 2162–2170. [Google Scholar] [CrossRef]
- Dutbayev, Y.; Kuldybayev, N.; Daugaliyeva, S.; Ismailova, E.; Sultanova, N.; Özer, G.; Slyamova, A.; Mukin, K.; Dababat, A.; Yessimbekova, M. Occurrence of Spot Blotch in Spring Barley Caused by Bipolaris sorokiniana Shoem. in South-Eastern Kazakhstan. Sci. World J. 2022, 2022, 3602996. [Google Scholar] [CrossRef]
- Sivanesan, A. Graminicolous Species of Bipolaris, Curvularia, Drechslera, Exerohilum and Their Teleomorphs; Mycological Paper No. 158; CAB International Mycological Institute: Wallingford, UK, 1987. [Google Scholar]
- Maraite, H.; Zinno, T.D.I.; Longree, H.; Daumerie, V.; Duvellier, E. Fungi association with foliar blight of wheat areas. In Helminthosporium Blights of Wheat: Spot Blotch and Tan Spot; Duvellier, E., Dubin, H.J., Reeves, J., McNab, A., Eds.; CIMMYT: Mexico City, Mexico, 1998; pp. 290–300. [Google Scholar]
- Zhao, W.; Chi, Y.M.; Wang, T.; Xu, A.; Qi, R. Development and application of recombinase polymerase amplification assay for detection of Bipolaris sorokiniana. Crop Prot. 2021, 145, 105619. [Google Scholar] [CrossRef]
- Zadoks, J.C.T.; Chang, T.T.; Konzak, C.F. A decimal code the growth stages of cereals. Weed Res. 1974, 14, 415–421. [Google Scholar] [CrossRef]
- Łacicowa, B. Metoda laboratoryjna szybkiej oceny odporności jęczmienia na Helminthosporium sativum P.K. et B. Biul. IHAR 1969, 3–4, 61–62. [Google Scholar]
- Meier, U. (Ed.) Growth stages of mono- and dicotyledonous plants. In BBCH Monograph, 2nd ed.; Federal Biological Research Centre for Agriculture and Forestry: Bonn, Germany, 2001; p. 158. [Google Scholar]
- International Rules for Seed Testing. Edition 2023; The International Seed Testing Association (ISTA): Bassersdorf, Switzerland, 2023.
- Barnett, H.L. Illustrated Genera of Imperfect Fungi; Burgess Pub. Company: Minneapolis, MN, USA, 1960; pp. 1–225. [Google Scholar]
- Chidambaram, S.B.; Matur, S.B.; Neergaard, P. Handbook on Seed Health Testing; The International Seed Testing Association As-NLH: Hamar, Norway, 1972; pp. 1–207. [Google Scholar]
- Ellis, M.B. Dematiaceous Hyphomycetes; Commonwealth Mycological Institute: Surrey, UK, 1971. [Google Scholar]
- Kwaśna, H.; Chełkowski, J.; Zajkowski, P. Flora Polska. T. XXII. Grzyby niedoskonałe. In Strzępczakowe. Gruzełkowate. Sierpik (Fusarium); PAN Warszawa: Kraków, Poland, 1991; pp. 1–158. [Google Scholar]
- Malone, J.P.; Muskett, A.E. Seed-borne fungi. In Description of 77 Fungus Species, 3rd ed.; Sheppard, J.W., Ed.; ISTA: Zurich, Switzerland, 1997; pp. 1–191. [Google Scholar]
- Duveiller, E.; Gilchrist, L. Production constraints due to Bipolaris sorokiniana in wheat: Current situation and future prospects. In Wheat in Heat-Stressed Environments: Irrigated, Dry Areas and Rice-Wheat Farming Systems; Saunders, D.A., Hettel, G.P., Eds.; CIMMYT: Texcoco, Mexico, 1994; pp. 343–352. [Google Scholar]
- Srivastava, O.P.; Luthra, J.K.; Narula, P.N. Inheritance of seedling resistance to leaf blight of wheat. Indian J. Genet. Plant Breed. 1971, 45, 941–943. [Google Scholar]
- Duveiller, E.; Garcia, I.; Franco, J.; Toledo, J.; Crossa, J.; Lopez, F. Evaluating spot blotch resistance of wheat: Improving disease assessment under controlled conditions and in the field. In Helminthosporium Blights of Wheat: Spot Blotch and Tan Spot; Duveiller, E., Dubin, H.J., Reeves, J., McNab, A., Eds.; CIMMYT: Texcoco, Mexico, 1998; pp. 171–181. [Google Scholar]
- Joshi, A.K.; Chand, R.; Arun, B. Relationship of plant height and days to maturity with resistance to spot blotch in wheat. Euphytica 2002, 123, 221–228. [Google Scholar] [CrossRef]
- Baturo-Cieśniewska, A. Genetic viariability and pathogenicity among polish isolates of Bipolaris sorokiniana from spring barley. J. Plant Pathol. 2011, 93, 291–302. [Google Scholar]
- Baturo-Cieśniewska, A.; Grabowski, A.; Pańka, D. Diversity in the polish isolates of Drechslera teres in spring barley as determined through morphological features, mating types, reaction to control agents and RAPD markers. J. Plant Pathol. 2012, 94, 339–351. [Google Scholar]
- Kumar, J.; Schäfer, P.; Hückelhoven, R.; Langen, G.; Baltruschat, H.; Stein, E.; Nagarajan, S.; Kogel, K.H. Bipolaris sorokiniana, a cereal pathogen of global concern: Cytological and molecular approaches towards better control‡. Mol. Plant Pathol. 2002, 3, 185–195. [Google Scholar] [CrossRef]
- Li, Q.; Gao, C.; Xu, K.; Jiang, Y.; Niu, J.; Yin, G.; Chenyang Wang, C. Transcriptome-based analysis of resistance mechanism to black point caused by Bipolaris sorokiniana in wheat. Sci. Rep. 2021, 11, 6911. [Google Scholar] [CrossRef]
- Ulukapi, K.; Nasircilar, A.G. Induced Mutation: Creating Genetic Diversity in Plants. In Chapter 4 in Genetic Diversity in Plant Species—Characterization and Conservation; IntechOpen: London, UK, 2018; pp. 41–55. [Google Scholar] [CrossRef]
- Ganna, A.; Verweij, K.J.H.; Nivard, M.G.; Maier, R.; Wedow, R.; Busch, A.S.; Abdellaoui, A.; Guo, S.; Sathirapongsasuti, J.F.; Lichstenstein, P.; et al. Large-scale GWAS reveals insights into the genetic architecture of same-sex sexual behawior. Science 2019, 365, 6456. [Google Scholar] [CrossRef]
- Cammarano, D.; Ronga, D.; Francia, E.; Akar, T.; Al-Yassin, A.; Benbelkacem, A.; Grando, S.; Romagosa, I.; Stanca, A.M.; Pecchioni, N. Genetic and Management Effects on barley Yield and Phenology in the Mediterranean Basin. Front. Plant Sci. 2021, 12, 655406. [Google Scholar] [CrossRef]
- Hu, Y.; Barmeier, G.; Schmidhalter, U. Genetic Variation in Grain Yield and Quality Traits of Spring Malting Barley. Agronomy 2021, 11, 1177. [Google Scholar] [CrossRef]
- Bailey, K.L.; Duczek, L.J.; Potts, D.A. Inoculation of seeds with Bipolaris sorokiniana and soil fumigation methods to determine wheat and barley tolerance and yield losses caused by common root rot. Can. J. Plant Sci. 1997, 77, 691–698. [Google Scholar] [CrossRef][Green Version]
- Cane, S.F.; Hampton, J.G. The effects of Bipolaris sorokiniana on barley seed quality. Australas. Plant Pathol. 1990, 19, 26–29. [Google Scholar] [CrossRef]
- Nutter, F.W., Jr.; Pederson, V.D.; Timian, R.G. Relationship between seed infection by barley stripe mosaic virus and yield loss. Phytopathology 1984, 74, 363–366. [Google Scholar] [CrossRef]
- Balzur Rashid, A.Q.M. Effect of transmitted Bipolaris sorokiniana on the growth and survival of wheat seedlings. Indian Phytopathol. 1998, 51, 329–333. [Google Scholar]
- Kosiada, T. Influence of Ascochyta, Bipolaris, Drechslera, Fusarium inoculations on the germination, emergence and infection of barley leaves. Cereal Res. Commun. 2013, 41, 116–125. [Google Scholar] [CrossRef]
- Kurppa, A. Bipolaris sorokiniana on barley seed in Finland. J. Agric. Sci. Finl. 1984, 56, 174. [Google Scholar] [CrossRef][Green Version]
- Chaurasia, S.; Chand, R.; Joshi, A.K. Relative dominance of Alternaria triticina Pras. et Pra. and Bipolaris sorokiniana (Sacc.) Shoemaker, in different growth stage of wheat (T. aestivum L.). J. Plant Dis. Prot. 2000, 107, 176–181. [Google Scholar]
- Shrestha, K.K.; Timila, R.D.; Mahto, B.N.; Bimb, H.P. Disease incidence and disease loss due to foliar blight of wheat in Nepal. In Helminthosporium Blights of Wheat: Spot Blotch and Tan Spot; Duveiller, E., Dubin, H.J., Reeves, J., McNab, A., Eds.; International Maize and Wheat Improvement Center: Mexico City, Mexico, 1998; pp. 67–72. [Google Scholar]

| Cultivar Name | Country of Origin | Breeder/Seed Provider |
|---|---|---|
| Antek | AUT | Probstdorfer Saatzucht GesmbH&Co. KG, Saatzuchtstraße, Austria |
| Barke | DEU | Saatzucht Josef Breun GmbH&Co. KG, Herzogenaurach, Germany |
| Bryl | POL | Hodowla Roślin Smolice Sp. z o.o Grupa IHAR, Smolice, Poland |
| Hanka | DEU | Lantmännen SW Seed Hadmersleben GmbH, Stockholm, Sweden |
| Johan | AUT | Probstdorfer Saatzucht GesmbH&Co. KG, Saatzuchtstraße, Austria |
| Justina | DEU | Nordsaat Saatzucht GmbH Saatzucht Langestein, Langenstein, Germany |
| Lailla | DEU | Lantmännen SW Seed Hadmersleben GmbH, Stockholm, Sweden |
| Prosa | AUT | Probstdorfer Saatzucht GesmbH&Co. KG, Saatzuchtstraße, Austria |
| Rastik | POL | Hodowla Roślin Smolice Sp. z o.o Grupa IHAR, Smolice, Poland |
| Refren | POL | Hodowla Roślin Smolice Sp. z o.o Grupa IHAR, Smolice, Poland |
| Ryton | POL | Hodowla Roślin Smolice Sp. z o.o Grupa IHAR, Smolice, Poland |
| Widawa | DEU | KWS Lochow GmbH, Bergen, Germany |
| BBCH Scale | Phase Description | Term Used in Article |
|---|---|---|
| BBCH 00 | dry seed (kernels) | kernels |
| BBCH 21–23 | beginning of tillering, from 1st to 3rd tiller visible | tillering |
| BBCH 31–33 | stem elongation—from 1st node to 3rd node at least 2 cm above 2nd node | stem elongation |
| BBCH 55 | heading phase: half of inflorescence emerged | heading |
| BBCH 65 | full flowering—50% anthers mature | flowering |
| Component of Variation | Traits Evaluated: | |||
|---|---|---|---|---|
| YPP | TKW | GC | SH | |
| cultivars (1) | 2.24 ** | 115.97 *** | 27.88 *** | 30.74 *** |
| different phases of plant inoculation (2) | ns | 34.43 *** | 60.71 *** | 224.22 *** |
| interaction (1) × (2) | ns | 3.78 *** | 2.98 *** | 6.70 *** |
| Cultivar | Inoculation in Following Development Phases: | Mean for Cultivar | F-Value (Difference between Treatments) | |||||
|---|---|---|---|---|---|---|---|---|
| Name | Control (No Inoculation) | Kernels | Tillering | Stem Elongation | Heading | Flowering | ||
| Antek | 0.77 ± 0.10 | 0.81 ± 0.26 | 0.77 ± 0.19 | 0.74 ± 0.26 | 0.77 ± 0.23 | 0.71 ± 0.19 | 0.76 ± 0.08 a | ns |
| Barke | 0.67 ± 0.15 | 0.76 ± 0.25 | 0.64 ± 0.16 | 0.72 ± 0.23 | 0.69 ± 0.15 | 0.75 ± 0.24 | 0.70 ± 0.09 ab | ns |
| Bryl | 0.66 ± 0.25 | 0.69 ± 0.26 | 0.62 ± 0.17 | 0.61 ± 0.21 | 0.67 ± 0.19 | 0.69 ± 0.22 | 0.65 ± 0.15 b | ns |
| Hanka | 0.61 ± 0.19 | 0.70 ± 0.29 | 0.65 ± 0.17 | 0.72 ± 0.20 | 0.69 ± 0.24 | 0.74 ± 0.24 | 0.68 ± 0.15 ab | ns |
| Johan | 0.71 ± 0.20 | 0.66 ± 0.24 | 0.68 ± 0.21 | 0.57 ± 0.17 | 0.65 ± 0.14 | 0.65 ± 0.22 | 0.65 ± 0.12 b | ns |
| Justina | 0.66 ± 0.27 | 0.71 ± 0.24 | 0.63 ± 0.14 | 0.72 ± 0.22 | 0.68 ± 0.20 | 0.67 ± 0.19 | 0.68 ± 0.14 ab | ns |
| Lailla | 0.61 ± 0.21 | 0.63 ± 0.21 | 0.64 ± 0.18 | 0.61 ± 0.18 | 0.65 ± 0.23 | 0.59 ± 0.21 | 0.62 ± 0.14 c | ns |
| Prosa | 0.66 ± 0.26 | 0.61 ± 0.18 | 0.63 ± 0.20 | 0.68 ± 0.24 | 0.65 ± 0.23 | 0.62 ± 0.26 | 0.64 ± 0.15 b | ns |
| Rastik | 0.54 ± 0.14 | 0.51 ± 0.17 | 0.47 ± 0.12 | 0.48 ± 0.19 | 0.49 ± 0.12 | 0.48 ± 0.16 | 0.49 ± 0.11 d | ns |
| Refren | 0.69 ± 0.24 | 0.68 ± 0.24 | 0.65 ± 0.17 | 0.65 ± 0.22 | 0.65 ± 0.21 | 0.66 ± 0.26 | 0.66 ± 0.14 b | ns |
| Ryton | 0.65 ± 0.14 | 0.76 ± 0.27 | 0.66 ± 0.14 | 0.67 ± 0.21 | 0.69 ± 0.20 | 0.73 ± 0.20 | 0.69 ± 0.11 ab | ns |
| Widawa | 0.82 ± 0.22 | 0.76 ± 0.18 | 0.71 ± 0.21 | 0.74 ± 0.25 | 0.80 ± 0.22 | 0.81 ± 0.25 | 0.77 ± 0.10 a | ns |
| Mean for treatments | 0.67 A | 0.69 A | 0.64 A | 0.66 A | 0.67 A | 0.67 A | 0.67 | |
| F-value (difference between cultivars) | ns | ns | ns | ns | ns | ns | 3.79 *** | |
| Cultivar Name | Treatments: | Mean for Cultivar | F-Value (Difference between Treatments) | |||||
|---|---|---|---|---|---|---|---|---|
| Control (No Inoculation) | Inoculation at Following Development Stages: | |||||||
| Kernels | Tillering | Stem Elongation | Heading | Flowering | ||||
| Antek | 26.7 ± 1.25 | 27.0 ± 0.45 | 26.1 ± 0.78 | 27.3 ± 0.52 | 26.1 ± 0.61 | 26.8 ± 0.35 | 26.7 ± 0.8 b | ns |
| Barke | 28.2 ± 0.30 | 25.5 ± 0.17 | 25.4 ± 0.67 | 26.2 ± 0.36 | 25.9 ± 0.27 | 26.4 ± 0.22 | 26.3 ± 0.6 bc | 12.64 *** |
| Bryl | 27.5 ± 0.29 | 27.8 ± 0.20 | 26.6 ± 0.50 | 27.0 ± 0.17 | 27.3 ± 0.18 | 27.7 ± 0.59 | 27.3 ± 0.9 a | 33.28 *** |
| Hanka | 26.3 ± 0.93 | 25.7 ± 0.29 | 25.2 ± 0.27 | 24.9 ± 0.24 | 24.6 ± 0.17 | 24.9 ± 0.63 | 25.3 ± 0.8 c | 9.50 *** |
| Johan | 24.9 ± 0.50 | 24.4 ± 0.30 | 23.9 ± 1.06 | 24.3 ± 0.26 | 25.0 ± 1.28 | 24.3 ± 0.47 | 24.5 ± 0.8 d | ns |
| Justina | 26.7 ± 0.59 | 25.7 ± 0.19 | 24.7 ± 0.16 | 26.1 ± 0.45 | 26.7 ± 0.32 | 26.3 ± 0.59 | 26.1 ± 0.8 c | 18.66 *** |
| Lailla | 25.7 ± 1.25 | 25.6 ± 0.34 | 24.8 ± 0.15 | 25.5 ± 0.33 | 25.8 ± 0.69 | 24.8 ± 0.23 | 25.3 ± 0.7 c | ns |
| Prosa | 25.2 ± 0.46 | 24.5 ± 0.27 | 24.1 ± 0.78 | 25.1 ± 0.77 | 23.8 ± 0.51 | 24.9 ± 0.60 | 24.6 ± 0.6 d | ns |
| Rastik | 25.6 ± 0.26 | 24.4 ± 0.20 | 24.7 ± 1.28 | 25.6 ± 0.25 | 25.2 ± 0.61 | 24.8 ± 0.27 | 25.1 ± 0.8 c | 4.76 ** |
| Refren | 26.0 ± 0.55 | 24.4 ± 0.33 | 23.5 ± 0.12 | 24.3 ± 0.72 | 24.3 ± 0.65 | 24.1 ± 0.49 | 24.4 ± 0.7 de | 4.91 ** |
| Ryton | 25.8 ± 0.53 | 24.0 ± 0.34 | 22.6 ± 0.35 | 23.3 ± 0.91 | 24.1 ± 1.00 | 24.5 ± 0.30 | 24.0 ± 0.9 e | 6.28 ** |
| Widawa | 24.5 ± 0.45 | 27.5 ± 0.32 | 25.4 ± 0.34 | 26.3 ± 0.76 | 27.5 ± 0.39 | 26.9 ± 0.22 | 26.4 ± 0.8 b | 13.58 *** |
| Mean for treatment | 26.08 A | 25.55 B | 24.75 C | 25.50 B | 25.53 B | 25.54 B | 25.49 | |
| F-value (difference between cultivars) | 12.18 *** | 97.07 *** | 15.10 *** | 23.54 *** | 18.62 *** | 37.06 *** | 6.88 *** | |
| Cultivar Name | Treatments: | Mean for Cultivar | F-Value (Difference between Treatments) | |||||
|---|---|---|---|---|---|---|---|---|
| Control | Inoculation at Following Development Stages: | |||||||
| (No Inoculation) | Kernels | Tillering | Stem Elongation | Heading | Flowering | |||
| Antek | 65.3 ± 5.0 | 69.3 ± 4.2 | 51.3 ± 13.3 | 76.7 ± 8.1 | 84.7 ± 1.2 | 89.3 ± 4.6 | 72.8 ± 6.1 | 11.2 *** |
| Barke | 75.3 ± 7.6 | 76.7 ± 4.2 | 62.0 ± 5.3 | 70.0 ± 9.2 | 86.7 ± 5.0 | 87.3 ± 1.2 | 76.3 ± 5.4 | 8.0 ** |
| Bryl | 82.7 ± 3.1 | 81.3 ± 6.4 | 80.7 ± 2.3 | 76.7 ± 1.2 | 88.7 ± 5.0 | 86.7 ± 7.0 | 82.8 ± 4.2 | ns |
| Hanka | 79.3 ± 3.3 | 78.7 ± 5.0 | 58.0 ± 2.0 | 64.0 ± 11.1 | 78.0 ± 5.3 | 73.3 ± 3.1 | 71.9 ± 4.9 | 7.1 ** |
| Johan | 76.0 ± 2.0 | 68.7 ± 7.6 | 40.0 ± 6.0 | 65.3 ± 9.9 | 81.3 ± 7.0 | 88.0 ± 0.8 | 69.9 ± 5.4 | 20.8 *** |
| Justina | 84.0 ± 2.0 | 80.7 ± 2.3 | 76.0 ± 8.0 | 69.3 ± 6.1 | 91.3 ± 3.1 | 93.3 ± 1.2 | 82.4 ± 3.8 | 12.4 *** |
| Lailla | 76.0 ± 1.9 | 70.0 ± 7.2 | 60.0 ± 8.7 | 68.7 ± 9.0 | 75.3 ± 7.0 | 82.0 ± 7.2 | 72.0 ± 6.9 | 3.3 ** |
| Prosa | 78.0 ± 5.3 | 84.0 ± 3.5 | 70.7 ± 3.1 | 86.7 ± 5.8 | 83.3 ± 10.3 | 88.0 ± 2.0 | 81.8 ± 5.0 | 3.9 ** |
| Rastik | 64.0 ± 5.3 | 47.3 ± 1.2 | 48.7 ± 7.0 | 50.0 ± 5.3 | 59.3 ± 4.6 | 70.7 ± 8.1 | 56.7 ± 5.2 | 8.4 ** |
| Refren | 82.7 ± 2.3 | 64.7 ± 6.1 | 66.7 ± 15.3 | 80.0 ± 0.9 | 84.0 ± 2.0 | 82.7 ± 3.1 | 76.8 ± 4.8 | 4.7 ** |
| Ryton | 76.7 ± 1.2 | 66.7 ± 4.2 | 63.3 ± 5.0 | 62.0 ± 4.0 | 74.7 ± 9.0 | 84.0 ± 5.3 | 71.2 ± 4.8 | 7.9 ** |
| Widawa | 84.0 ± 2.0 | 78.0 ± 5.3 | 75.3 ± 9.5 | 81.3 ± 3.1 | 82.7 ± 4.2 | 86.0 ± 5.3 | 81.2 ± 4.9 | ns |
| Mean for treatment | 77.0 B | 72.2 BC | 62.7 C | 70.9 AB | 80.8 AB | 84.3 A | 74.6 | 20.74 *** |
| F-value (difference between cultivars) | 8.70 *** | 11.76 *** | 6.61 *** | 6.29 *** | 6.10 *** | 5.66 *** | 7.01 *** | |
| Species | Seed Infection Rate (No. of Colonies per 100 Seeds) from Different Treatments (i.e., Plant Infection with Bipolaris at Different Phases of Development): | ||||||
|---|---|---|---|---|---|---|---|
| Control | Kernels | Tillering | Stem Elongation | Heading | Flowering | Mean | |
| Alternaria alternata (Fr.) Keissler | 75.7 ± 7.3 a | 74.1 ± 4.6 a | 68.8 ± 9.9 b | 45.8 ± 7.8 c | 27.6 ± 7.1 d | 78.2 ± 6.8 a | 61.7 ± 19.9 |
| Bipolaris sorokiniana (Sacc.) Shoem. | 10.5 ± 4.7 e | 17.7 ± 4.3 d | 27.2 ± 9.4 c | 25.4 ± 11.2 c | 58.3 ± 9.6 b | 81.9 ± 6.7 a | 36.8 ± 26.3 |
| Aureobasidium pullulans (dre Bary) G. Arnoud | 7.2 ± 1.2 a | 7.6 ± 1.9 a | 11.4 ± 3.2 a | 4.5 ± 1.0 c | 2.3 ± 0.6 d | 12.1 ± 2.1 a | 7.5 ± 4.6 |
| Fusarium equiseti (Corda) Sacc. | 9.5 ± 2.7 a | 4.7 ± 1.3 b | 6.2 ± 1.4 ab | 5.1 ± 1.9 b | 4.2 ±0.9 b | 6.8 ± 2.0 ab | 6.1 ± 3.8 |
| Stemphylium consortiale (Thüm.) Gr. et Skol. | 7.0 ± 2.8 a | 4.8 ± 1.1 b | 6.5 ± 1.9 ab | 5.0 ± 2.0 b | 2.4 ± 0.5 c | 8.5 ± 3.0 a | 5.71 ± 3.1 |
| Epicoccum nigrum Link. | 6.8 ± 2.9 a | 7.0 ± 3.5 a | 6.3 ± 1.8 a | 2.6 ± 0.9 b | 1.7 ± 0.1 b | 6.9 ± 2.0 a | 5.2 ± 3.1 |
| Fusarium solani (Mart.) Sacc. | 1.8 ± 0.3 b | 1.6 ± 0.2 b | 1.0 ± 0.2 b | 1.6 ± 0.1 b | 1.8 ± 0.3 b | 3.3 ± 1.1 a | 1.8 ± 1.8 |
| Fusarium semitectum Berkeley and Ravenel | 2.6 ± 0.5 | 1.7 ± 1.0 | 1.1 ± 0.9 | 1.6 ± 0.5 | 0.9 ± 0.3 | 2.0 ± 1.0 | 1.6 ± 1.5 |
| Phoma sp. | 1.2 ± 0.4 bc | 1.2 ± 0.5 c | 1.8 ± 0.9 b | 0.9 ± 0.4 c | 0.2 ± 0.1 d | 2.9 ± 0.9 a | 1.4 ± 1.3 |
| Fusarium sporotrichioides Sherb. | 1.4 ± 0.6 | 1.2 ± 0.7 | 1.4 ± 0.6 | 1.0 ± 0.7 | 0.9 ± 0.4 | 1.8 ± 0.5 | 1.3 ± 1.3 |
| Fusarium oxysporum Schltdl | 2.2 ± 0.9 a | 1.0 ± 0.6 a | 1.3 ± 0.8 a | 0.1 ± 0.04 b | 1.0 ± 0.4 a | 1.8 ± 0.9 a | 1.2 ± 1.5 |
| Fusarium poae (Peck) Wollenw. | 2.2 ± 0.8 a | 0.7 ± 0.2 b | 0.7 ± 0.1 b | 1.3 ± 0.9 ab | 0.4 ± 0.1 b | 2.0 ± 0.3 a | 1.2 ± 1.6 |
| Penicillium spp. | 0.5 ± 0.2 | 1.4 ± 1.0 | - | 0.4 ± 0.2 | 0.7 ± 0.2 | 1.3 ± 0.9 | 0.7 ± 1.3 |
| Cladosporium herbarum (Pers.) Link | 1.2 ± 0.9 | 0.7 ± 0.3 | 0.9 ± 0.4 | 0.4 ± 0.2 | 0.3 ± 0.1 | 0.4 ± 0.3 | 0.7 ± 1.1 |
| Fusarium culmorum (Wm.G. Sm.) Sacc. | 0.2 ± 0.1 | 0.9 ± 0.7 | 0.6 ± 0.5 | 0.6 ± 0.3 | 0.2 ± 0.1 | 0.5 ± 0.3 | 0.5 ± 0.9 |
| Stemphylium botryosum Wallr. | 0.4 ± 0.3 | 0.6 ± 0.4 | 0.7 ± 0.3 | 0.2 ± 0.1 | 0.2 ± 0.1 | 0.8 ± 0.7 | 0.5 ± 0.8 |
| Sordaria fimicola (Roberge ex Desm.) Ces. & De Not. | 0.6 ± 0.4 | 0.4 ± 0.3 | 0.3 ± 0.2 | 0.7 ± 0.3 | - | 0.7 ± 0.2 | 0.5 ± 0.9 |
| Fusarium avenaceum (Fr.) Sacc. | 0.6 ± 0.2 a | 0.1 ± 0.07 b | 0.8 ± 0.3 a | 0.3 ± 0.1 b | 0.1 ± 0.06 b | 0.9 ± 0.3 a | 0.4 ± 0.8 |
| Drechslera teres (Sacc.) Shoemaker | 0.3 ± 0.2 a | 0.7 ± 0.2 a | 0.6 ± 0.2 a | 0.1 ± 0.1 b | - | 0.8 ± 0.3 a | 0.4 ± 0.8 |
| Fusarium verticillioides (Sacc.) Nierenberg | 0.2 ± 0.3 b | 0.3 ± 0.1 b | 0.3 ± 0.1 b | 1.0 ± 0.3 a | 0.2 ± 0.2 b | 0.1 ± 0.1 c | 0.3 ± 0.6 |
| Rhizoctonia solani J.G. Kuhn | 0.4 ± 0.1 | 0.7 ± 0.9 | 0.3 ± 0.6 | 0.2 ± 0.4 | - | 0.2 ± 0.6 | 0.3 ± 0.6 |
| Nigrospora oryzae (Berk & Br.) Petch | 0.8 ± 0.6 a | 0.3 ± 0.8 a | 0.2 ± 0.4 b | - | 0.1 ± 0.3 b | 0.4 ± 0.7 a | 0.3 ± 0.5 |
| Acremonium spp. | 0.7 ± 1.1 | 0.4 ± 0.7 | 0.1 ± 0.3 | 0.1 ± 0.3 | - | 0.5 ± 1.0 | 0.3 ± 0.4 |
| Papularia arundinis (Corda) Fr. | 0.3 ± 0.9 | 0.2 ± 0.6 | 0.4 ± 1.1 | 0.2 ± 0.6 | 0.1 ± 0.3 | 0.3 ± 0.5 | 0.2 ± 0.3 |
| Fusarium graminearum Schwabe | 0.7 ± 1.4 | - | 0.3 ± 0.8 | 0.1 ± 0.3 | - | 0.2 ± 0.4 | 0.2 ± 0.2 |
| Fusarium tricinctum (Corda) Sacc. | 0.2 ± 0.4 | - | 0.4 ± 0.8 | - | - | 0.2 ± 0.6 | 0.1 ± 0.2 |
| Arthrobotrys superbus Corda | 0.2 ± 0.6 | 0.1 ± 0.3 | 0.2 ± 0.6 | 0.1 ± 0.3 | - | 0.2 ± 0.6 | 0.1 ± 0.1 |
| Trichothecium roseum (Pers.) Link | 0.3 ± 0.8 | 0.1 ± 0.3 | - | - | - | - | 0.1 ± 0.1 |
| Chaetomium sp. | 0.2 ± 0.4 | 0.2 ± 0.4 | - | - | - | - | 0.1 ± 0.1 |
| Botrytis cinerea Pers. ex Fr. | 0.1 ± 0.2 | - | 0.1 ± 0.2 | - | - | 0.2 ± 0.4 | 0.1 ± 0.1 |
| Drechslera dematioidea (Bubák & Wróbl.) Scharif | - | 0.1 ± 0.3 | 0.2 ± 0.4 | - | - | - | 0.04 ± 0.01 |
| Aspergillus spp. | - | - | - | - | 0.2 ± 0.4 | - | 0.04 ± 0.02 |
| Trichoderma viride Pers. | - | - | - | 0.2 ± 0.3 | 0.1 ± 0.2 | - | 0.04 ± 0.01 |
| Mucor sp. | - | - | 0.2 ± 0.4 | - | - | 0.1 ± 0.2 | 0.04 ± 0.04 |
| Ascochyta sp. | - | 0.2 ± 0.4 | - | - | - | - | 0.03 ± 0.03 |
| Papulaspora sp. | - | - | - | - | 0.1 ± 0.2 | 0.1 ± 0.2 | 0.03 ± 0.02 |
| Curvularia lunata (Wakker) Boedijn | 0.1 ± 0.2 | - | - | - | - | - | 0.01 ± 0.02 |
| non-sporulating mycelium | 0.4 ± 0.9 | 0.1 ± 0.3 | 0.2 ± 0.6 | 0.2 ± 0.6 | - | 0.2 ± 0.4 | 0.18 ± 0.3 |
| Bacteria (species not recognized) | 29.3 ± 4.3 a | 27.7 ± 7.4 a | 30.1 ± 6.0 a | 28.0 ± 4.5 a | 20.8 ± 4.5 b | 26.2 ± 4.2 a | 27.0 ± 12.1 |
| Total microorganisms | 174.7 ± 4.1 a | 167.7 ± 3.2 b | 169.8 ± 6.2 a | 160.6 ± 6.1 b | 148.6 ± 7.1 c | 178.2 ± a | 166.6 |
| Cultivar Name | Treatments: | Mean for Cultivar | F-Value (Difference between Treatments) | |||||
|---|---|---|---|---|---|---|---|---|
| Control | Inoculation at Following Development Stages: | |||||||
| Kernels | Tillering | Stem Elongation | Heading | Flowering | ||||
| Antek | 17 ± 3 | 24 ± 1 | 32 ± 2 | 28 ± 4 | 74 ± 4 | 81 ± 5 | 42.7 ± 6.1 | 194.8 *** |
| Barke | 11 ± 1 | 14 ± 4 | 45 ± 3 | 44 ± 4 | 68 ± 2 | 93 ± 3 | 45.8 ± 7.0 | 323.8 *** |
| Bryl | 6 ± 1 | 11 ± 5 | 24 ± 4 | 36 ± 4 | 63 ± 5 | 83 ± 1 | 37.2 ± 6.8 | 167.2 *** |
| Hanka | 17 ± 3 | 16 ± 2 | 18 ± 2 | 48 ± 2 | 56 ± 6 | 82 ± 4 | 39.5 ± 6.1 | 181.1 *** |
| Johan | 6 ± 0 | 19 ± 5 | 19 ± 5 | 21 ± 4 | 57 ± 3 | 75 ± 3 | 32.8 ± 6.0 | 87.1 *** |
| Justina | 16 ± 0 | 14 ± 6 | 32 ± 2 | 18 ± 2 | 39 ± 1 | 71 ± 1 | 31.7 ± 4.8 | 183.5 *** |
| Lailla | 9 ± 1 | 19 ± 5 | 31 ± 7 | 16 ± 6 | 48 ± 2 | 80 ± 4 | 33.8 ± 5.9 | 96.4 *** |
| Prosa | 9 ± 1 | 21 ± 3 | 39 ± 5 | 17 ± 3 | 61 ± 5 | 85 ± 1 | 38.7 ± 6.5 | 131.4 *** |
| Rastik | 6 ± 1 | 13 ± 2 | 19 ± 1 | 18 ± 1 | 50 ± 8 | 78 ± 4 | 30.7 ± 6.2 | 113.1 *** |
| Refren | 6 ± 1 | 19 ± 1 | 33 ± 1 | 22 ± 4 | 67 ± 5 | 75 ± 3 | 37.0 ± 6.2 | 120.1 *** |
| Ryton | 7 ± 2 | 25 ± 4 | 15 ± 3 | 20 ± 1 | 55 ± 3 | 91 ± 5 | 35.5 ± 7.1 | 145.2 *** |
| Widawa | 16 ± 3 | 17 ± 5 | 20 ± 4 | 17 ± 1 | 62 ± 4 | 89 ± 3 | 36.8 ± 5.2 | 210.7 *** |
| Mean for treatment | 10.5 E | 17.7 D | 27.3 C | 25.4 C | 58.3 B | 81.9 A | 36.8 | |
| F-value (difference between cultivars) | 8.46 *** | 2.49 ** | 19.68 *** | 15.68 *** | 14.33 *** | 11.96 *** | ns | |
| Fungus Species | Germination Capacity (GC) | B. sorokiniana Seed Infection | ||
|---|---|---|---|---|
| Acremonium spp. | 0.12 | −0.27 | ** | |
| Alternaria alternata | −0.05 | −0.95 | *** | |
| Ascochyta sp. | −0.29 | ** | −0.08 | |
| Aspergillus spp. | −0.09 | 0.28 | ** | |
| Aureobasidium pullulans | −0.14 | −0.64 | *** | |
| Bipolaris sorokiniana | −0.63 | *** | x | |
| Chaetomium sp. | −0.27 | ** | −0.12 | |
| Cladosporium herbarum | −0.39 | *** | −0.25 | ** |
| Drechslera dematioidea | −0.25 | ** | −0.08 | |
| Drechslera teres | −0.15 | −0.32 | *** | |
| Epicoccum nigrum | −0.05 | −0.71 | *** | |
| Fusarium avenaceum | 0.06 | −0.31 | *** | |
| Fusarium equiseti | 0.13 | −0.35 | *** | |
| Fusarium graminearum | 0.09 | −0.26 | ** | |
| Fusarium oxysporum | 0.19 | −0.31 | *** | |
| Fusarium poae | 0.16 | −0.27 | ** | |
| Fusarium semitectum | 0.21 | −0.29 | ** | |
| Fusarium solani | 0.36 | *** | −0.11 | |
| Nigrospora oryzae | −0.06 | −0.39 | *** | |
| Phoma sp. | 0.15 | −0.50 | *** | |
| Fusarium sp. (total) | 0.29 | ** | −0.46 | *** |
| Stemphylium consortiale | −0.04 | −0.56 | *** | |
| Bacteria | −0.38 | *** | −0.37 | *** |
Disclaimer/Publisher’s Note: The statements, opinions and data contained in all publications are solely those of the individual author(s) and contributor(s) and not of MDPI and/or the editor(s). MDPI and/or the editor(s) disclaim responsibility for any injury to people or property resulting from any ideas, methods, instructions or products referred to in the content. |
© 2024 by the authors. Licensee MDPI, Basel, Switzerland. This article is an open access article distributed under the terms and conditions of the Creative Commons Attribution (CC BY) license (https://creativecommons.org/licenses/by/4.0/).
Share and Cite
Wiewióra, B.; Żurek, G. The Infection of Barley at Different Growth Stages by Bipolaris sorokiniana and Its Effect on Plant Yield and Sowing Value. Agronomy 2024, 14, 1322. https://doi.org/10.3390/agronomy14061322
Wiewióra B, Żurek G. The Infection of Barley at Different Growth Stages by Bipolaris sorokiniana and Its Effect on Plant Yield and Sowing Value. Agronomy. 2024; 14(6):1322. https://doi.org/10.3390/agronomy14061322
Chicago/Turabian StyleWiewióra, Barbara, and Grzegorz Żurek. 2024. "The Infection of Barley at Different Growth Stages by Bipolaris sorokiniana and Its Effect on Plant Yield and Sowing Value" Agronomy 14, no. 6: 1322. https://doi.org/10.3390/agronomy14061322
APA StyleWiewióra, B., & Żurek, G. (2024). The Infection of Barley at Different Growth Stages by Bipolaris sorokiniana and Its Effect on Plant Yield and Sowing Value. Agronomy, 14(6), 1322. https://doi.org/10.3390/agronomy14061322

